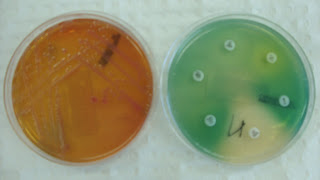

|
继前一阵关于MRSA(Methicillin Resistant Satphylococcus Aureus)的诸多报导, 人们对一种叫VRE(Vancomycin Resistant Enterococi)的菌突然谈”菌”色变, 以至于前几天关于美国出现一种叫CRE(Carbapenem Resistant Enterobacteriaceae)的超级细菌的传言甚嚣尘上. 第一例CRE在四年前在美国被发现, 如今澳洲,加拿大也发现报导了.随着大量抗生素的不合理使用, 出现耐药菌是不可避免的. 好在我们依旧有杀手锏: Vancomycin足以对付MRSA, Linezolid可杀死VRE, Polymyxins和Tigecycline都对CRE有效. (MRSA 的药敏)  (VRE让蓝色的培养液变成黑色) 要避免所谓的超级细菌出现, 需要社会,医疗从业人员一起努力.第一, 世界上总是一物克一物. 我们不能生活在真空中, 身上正常的寄生菌往往可抑制致病菌, 比如口腔, 胃肠和阴道的正常菌群并不致病, 反而抑制其它病原生长. 平时一些小伤口小感染, 相反可刺激人体免疫系统. 运动或惊吓引起的应急反应也是件好事了.第二, 今天我们无可避免地被动摄入二手抗菌素,由于农民在给牲口以至于河鲜的饲料中,添加了大量的抗生素.除了大家呼吁立法去限制这种短视行为, 监督有关部门是否行使职权外, 如果感染病毒, 或自我抑制性细菌疾病, 如腹泻,记得别服抗菌素. 第三, 抗菌素剂量过大有副作用,过低不能对细菌斩草除根, 一小撮漏网之鱼, 快速基因突变后, 进化成耐药菌了. VRE就是滥用头孢立新的恶果. 作为政府与医疗机构, 必须制定出公共卫生政策, 监督强化执行,建立教育议程. 澳洲58年起每年一版官方抗生素使用指南.各医院有药物使用委员会, 决定或否决药物使用, 基于理由如下: 1. 使用此抗生素的好处必须被科学地证明且是巨大的. 2.不能用广谱, 只用刚刚好针对此致病菌. 3. 每次用单一药, 除非为了增强药性, 防止耐药性,才联合用药. 4. 剂量要高到不至于出现耐药性, 或低到不至于出现毒副作用. 5. 要考虑到医药成本和病人花销. 6. 药物选择是基于培养和药敏试验的结果, 或基于已知的通常病原. 这一点, 大陆医院是做得很差的. 无从得知大陆是否起草了抗菌素使用指南. 过去几年向大陆同行推荐了几部澳洲的法律,都不了了之. 推荐了质量管理的软件, 因不能带来收费提高而婉拒. 举办一场抗生素使用讲座, 同学同仁聊无兴趣. 种种景象, 令人堪忧.本人八十年代在中国骨科的经历, 不时掠过脑际. 那是在滨海城市一家法国天主教留下的医院, 其中一个进修医生C,完成了全世界第一例断指再植, 而闻名于世. 那个医师自然成了另一医院的骨科主任, 最后他因忘记带自家钥匙而爬楼翻窗, 不慎悲剧性地跌落摔死, 则是后话. 文革动荡年代,外科主任改行做医院的花匠, 而除草的却硬被培养成主刀医师. 其中一位时任主治医师,无敬业精神可言, 手术事故不少,却无人追究. 中国的病人是最可怜的, 绝对不对称的毫不掌握病情和治疗资讯. 文革后, 基本上论毕业年份升职称, C医生的导师T成了科主任.我则在我师兄F手下实习. 可能是与世隔绝了几十年,没有章法可循, 或是大家无心向学. 反正今天的大陆大同小异, 那时人人读英语想出国, 现在个个变法子想赚钱. 那时病房由门诊收进了一个高大威猛的小伙子, 脚趾感染久治不愈. 当时已知是绿脓杆菌(见附图下,呈绿色,带着香水味).F兄如临大敌,每次换药都戴口罩, 帽子, 手套和隔离衣,换药后再摘下, 然后焚毁. T主任指示给予当时最新的阿莫西林药片, 可是感染不可控制地蔓延到整个脚背.开刀是本科的拿手好戏,于是切除了右足. 但是伤口收不了口.T主任又指示F兄,改用氨苄青霉素针剂.依然无济于事.可以想象的是,为了防止感染进一步扩散,截除小腿. 今天我就是用屁股想都知道, 绿脓杆菌除了对诺福沙星家族敏感, 对其它抗菌素一概抵抗. 可是当时所有上级, 偏偏没有一人知道. 更可怕的是不懂装懂, 或用猜的去取代药敏培养试验. 更令人担心的是二十年后的中国依然如故, 如果你有亲人还在大陆, 或你有机会因去大陆旅游而住院, 很有可能误治中招. 言归正传. T主任的思路仍停留在浓度, 而非敏感度上,命令我们直接将针剂的粉末, 洒在大腿溃疡上. 当然那只是在错误的道路上走得更大步和有力些罢了.在我离开医院时, 可怜的小伙子的大腿已被截肢,感染已进入盆腔. 生命堪忧. (绿脓杆菌的培养和药敏试验) 前年回国, 特地回医院见F兄. 老兄有自知之明, 放弃学英语出国, 如今已升为副主任医师了.谈起我认为的当年一起起事故, 他一脸茫然. 今天医生还是按照医药销售员提供的宣传单, 开药”治病”. 培养和药敏还是不做的. 超级细菌是可怕, 但因其仍可治性, 而又不可怕.缺乏基本的西方现代医疗知识, 又不好学进取, 也没有提供持续教育的系统, 同时缺乏健全的医疗制度和监督机构, 犯下了多少医疗事故, 都没有统计, 赔偿,何从谈起如何避免不必要的事故呢? 于是, 不必要的痛苦, 以至于死亡的发生, 才是最可怕的. 网上有中医取消论. 不知西医传到中国, 国人学到了多少治病救人的精髓,和慈悲忘我的胸怀? 还是仅仅作为生财之道, 加以巧取豪夺. 如此先要抢救的不是病人, 而是医生和医疗行政官员了.中医和西医在中国的失败,在于我们文化的堕落. 追名逐利, 非追求科学真谛.即使读完了大学, 依然满脑子乡土文化, 双盲对照和统计处理全到了九霄云外.有限的物质生命, 终归与人一样化为腐朽. 那片土地上, 没有发明创新,没有认真求知, 后代也继承不到永恒的遗产. |
|